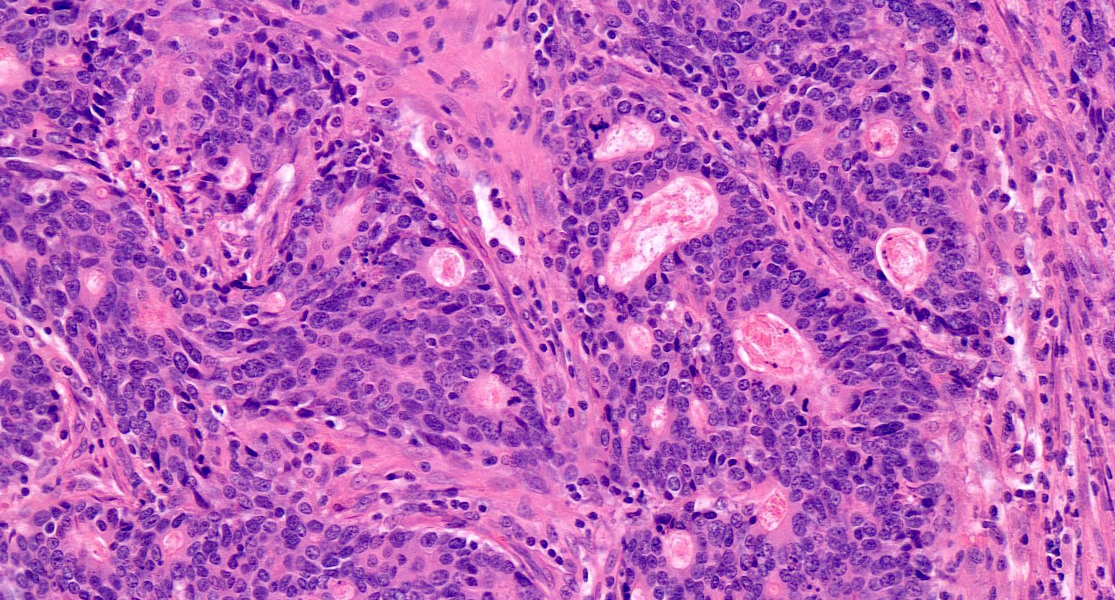

Table of Contents
Definition / general | Essential features | Terminology | ICD coding | Epidemiology | Sites | Pathophysiology | Etiology | Clinical features | Diagnosis | Laboratory | Radiology description | Radiology images | Prognostic factors | Case reports | Treatment | Clinical images | Gross description | Gross images | Frozen section description | Microscopic (histologic) description | Microscopic (histologic) images | Cytology description | Positive stains | Molecular / cytogenetics description | Sample pathology report | Differential diagnosis | Practice question #1 | Practice answer #1 | Practice question #2 | Practice answer #2Cite this page: Norton EJ, Bateman AC. Intestinal type adenocarcinoma. PathologyOutlines.com website. https://www.pathologyoutlines.com/topic/stomachintestinal.html. Accessed September 17th, 2025.
Definition / general
- Tubular and papillary histological subtypes of gastric adenocarcinoma were historically grouped together under the term intestinal adenocarcinoma
- Tubular adenocarcinoma is composed of neoplastic ducts of varying size and represents the most common subtype of this cancer
- Papillary adenocarcinoma comprises finger-like projections of well differentiated epithelial cells arranged around fibrovascular cores
Essential features
- Intestinal type (tubular and papillary) adenocarcinoma has a more favorable prognosis than other histological subtypes of gastric carcinoma
- Commonly associated with atrophic gastritis and gastric epithelial dysplasia
- May express HER2 or PDL1, both of which offer additional treatment options
Terminology
- Previously termed intestinal adenocarcinoma within the original Lauren classification (1965) (Acta Pathol Microbiol Scand 1965;64:31)
ICD coding
Epidemiology
- Gastric adenocarcinoma is the third most common cancer type worldwide
- Incidence is highest in Eastern Asia, Central and Eastern Europe and South America (CA Cancer J Clin 2015;65:87)
- Incidence is twice as high in men as compared to women (Cancer Epidemiol Biomarkers Prev 2010;19:1893)
- Overall, incidence is gradually declining across the world; however, adenocarcinoma of the gastric cardia is increasing in North America and Europe, which is hypothesized to be related to increasing obesity (Cancer Epidemiol Biomarkers Prev 2010;19:1893)
Sites
- In the highest incidence areas (see Epidemiology), the most common site is the distal stomach
- In northern Europe and the U.S., about half of the cases are located in the gastric cardia or fundus (Curr Gastroenterol Rep 2017;19:36)
- Metastases commonly occur in lymph nodes, liver, lungs, bones, peritoneum and less commonly in the ovary (Krukenberg tumor is a term used for bilateral ovarian involvement)
Pathophysiology
- Gastric atrophy caused by Helicobacter pylori associated gastritis or autoimmune gastritis leads to gastric hypochlorhydria and then to bacterial overgrowth in the stomach; this results in the generation of carcinogenic agents within the stomach, leading to neoplastic transformation within the gastric epithelium
- An increasing number of genetic and epigenetic alterations are implicated in the pathogenesis of gastric adenocarcinoma
- In the literature, 4 molecular subtypes of gastric adenocarcinoma have been described, each with distinct genomic features
- EBV positive: DNA hypermethylation, PIK3CA mutations, amplification of PDL1, PDL2 and JAK2
- Microsatellite unstable: high mutation rates including of mismatch repair genes, such as MLH1
- Genomically stable (associated with diffuse histology): inactivating mutations in the E-cadherin gene (CDH1) and mutations / fusions of RHOA
- Chromosomal instability (associated with intestinal histology): TP53 mutation and amplification of receptor tyrosine kinases (Nature 2014;513:202)
- Tumor spread occurs via direct invasion of adjacent structures, lymphatic or hematogenous spread or serosal dissemination
Etiology
- Risk factors include Helicobacter associated gastritis and autoimmune gastritis as well as cigarette smoking, working in the rubber manufacturing industry, Xray radiation and gamma radiation
- There is equivocal evidence for additional risk factors including EBV infection, dietary factors, asbestos, N nitroso and lead compounds
- Familial / hereditary tubular and papillary adenocarcinoma form a minority of cases and, unlike hereditary diffuse gastric cancer which is causally linked to CDH1 gene mutations, lack genetic testing guidelines when not associated with specific hereditary cancer susceptibility syndromes (Transl Gastroenterol Hepatol 2019;4:55)
- Notably, gastric adenocarcinoma and proximal polyposis of the stomach (GAPPS) is a recently described rare autosomal dominant familial gastric cancer (Best Pract Res Clin Gastroenterol 2021;50-51:101728)
Clinical features
- Symptoms include weight loss, abdominal pain, dyspepsia, early satiety, vomiting and in more proximal cancers, dysphagia
- May be asymptomatic (especially when at an early stage) or present with anemia only
- Signs of advanced disease on examination include cachexia, a palpable abdominal mass, an enlarged left supraclavicular node (Virchow node), left axillary node (Irish node) or periumbilical node (Sister Mary Joseph nodule)
- Common complications include upper gastrointestinal bleeds and gastric outlet obstruction
Diagnosis
- Upper gastrointestinal endoscopy commonly reveals a tumor mass or malignant ulcer within the stomach and allows biopsy for histological diagnosis, classification and evaluation of molecular biomarkers
- CT scan of the abdomen may reveal a tumor mass or malignant ulcer within the stomach; this should prompt endoscopy and biopsy
- CT scan of the chest, abdomen and pelvis is also used to detect metastatic spread and guide staging (see Radiology description)
Laboratory
- Histological examination is the key test for confirming the diagnosis
- Full blood count may show an iron deficiency anemia
- Biochemistry to assess renal and liver function may guide appropriate treatment options
Radiology description
- CT scanning and endoscopic ultrasonography (EUS) are important for radiological staging of the tumor (e.g., determining the operability of the primary tumor and looking for distant metastases)
- Additional investigations that can be considered to aid the detection of metastatic disease that may be missed by CT scanning, include positron emission tomography (PET) scans or a staging laparoscopy with peritoneal cytology (see Cytology description)
- See Diagnosis for a description of the role of radiology in the diagnosis of the primary lesion
Prognostic factors
- Tumor stage is the most important prognostic factor, especially nodal status; higher stages are associated with worse prognosis (Br J Cancer 2001;84:1602)
- Site of tumor: proximal gastric cancers have a worse prognosis than more distal cancers (Ann Surg 2000;232:353)
- Ulcerated tumors have a worse prognosis than polypoid (Pathol Oncol Res 2016;22:197)
- Histological subtype of adenocarcinoma: intestinal type has a favorable prognosis over other subtypes (J Gastrointest Oncol 2017;8:1026)
- High grade / poorly differentiated tumors have a worse prognosis (Cancer 2000;89:1418)
- Presence of perineural, lymphatic and vascular invasion is associated with a worse prognosis
- Response to neoadjuvant treatment is associated with a better prognosis
Case reports
- 49 year old woman with gastric tubular adenocarcinoma and SMAD4 germline pathogenic variant related juvenile polyposis syndrome (Am J Case Rep 2021;22:e932241)
- 61 year old man with cholangiocarcinoma combined with moderately differentiated gastric adenocarcinoma (Medicine (Baltimore) 2019;98:e16332)
- 65 year old man with synchronous gastric adenocarcinoma and perigastric lymph node metastatic squamous cell carcinoma with unknown primary (J Minim Invasive Surg 2020;23:99)
- 84 year old man with gastric adenocarcinoma of fundic gland (chief cell predominant type) coexisting with well differentiated intestinal adenocarcinoma (Medicine (Baltimore) 2021;100:e25861)
Treatment
- Tumors identified at a very early stage (i.e., pTis or pT1) may be amenable to local excision at upper gastrointestinal endoscopy
- Partial or complete gastrectomy may be required for tumors that are more locally advanced; this would almost always be associated with a regional lymphadenectomy
- Chemotherapy (with or without radiotherapy) may be given in an adjuvant or neoadjuvant setting for tumors assessed as at high risk of progressing with distant metastasis; this may include trastuzumab (Herceptin) for tumors shown to be HER2 positive on immunohistochemistry with or without in situ hybridization
- Immunotherapy has more recently become a treatment option (e.g., for tumors that are found to express PDL1 at above a treatment threshold level on immunohistochemistry) (Curr Oncol 2022;29:1559)
Gross description
- Tumors can vary in size from barely visible on macroscopic examination to several centimeters across
- Typical appearance would be as an ulcer with raised everted edges
- Alternative appearances would include an exophytic mass that may be polypoid in nature or an area of gastric wall thickening / stricturing
Gross images
Frozen section description
- Frozen section examination may be required if previously undetected distant lesions are identified during attempted surgical resection (e.g., within the peritoneum or liver)
- Appearance of the tumor on frozen section would mirror that seen in permanent sections (see Microscopic (histologic) description)
Microscopic (histologic) description
- Features:
- Tubular adenocarcinoma comprises haphazardly arranged neoplastic ducts of varying size and shape, often forming cribriform structures; the stroma is typically desmoplastic
- Areas of necrosis may be present
- Anastomosing / irregularly fused glands are present in a subgroup of cases and are associated with low grade cytological atypia, a poorly differentiated adenocarcinoma component and frequent RHOA and CDH1 mutations (Mod Pathol 2019;32:568)
- Tubular adenocarcinoma is the most common histological subtype of gastric adenocarcinoma
- Papillary adenocarcinoma comprises neoplastic epithelial cells, commonly well differentiated, arranged around fibrovascular cores forming elongated finger-like projections
- Papillary adenocarcinoma is a rare histological subtype of gastric adenocarcinoma
- Grading:
- Graded as low (formerly well differentiated) or high grade (formerly poorly differentiated) according to the World Health Organization Classification, 2019
- Staging (TNM 8th edition):
- T stage is dependent on how deeply the tumor has infiltrated the stomach wall; i.e., carcinoma in situ (Tis), invasion of the lamina propria or muscularis mucosae (T1a), submucosa (T1b), muscularis propria (T2), subserosa (T3), serosa / visceral peritoneum (T4a) or adjacent structures (T4b)
- N stage is dependent on how many regional lymph nodes are involved; i.e., none (N0), 1 - 2 nodes (N1), 3 - 6 nodes (N2), 7 - 15 nodes (N3a) or > 15 nodes (N3b)
- M stage is dependent on the presence of distant metastases; i.e., not present (M0) or present (M1) (Gastric Cancer 2018;21:643)
- Tumor regression grading (TRG):
- Tumor regression may be seen in resection specimens following neoadjuvant therapy
- Fibroinflammatory granulation tissue with foamy macrophages and dystrophic calcifications or acellular mucin lakes replace areas previously infiltrated by tumor and residual malignant cells may show marked nuclear atypia
- Evidence of tumor regression is associated with better prognosis and is commonly graded (Front Oncol 2013;3:262)
- The Mandard classification of TRG is dependent on the ratio of therapy induced fibrosis to residual tumor; i.e., no detectable tumor (TRG 1), scattered tumor cells (TRG 2), tumor cells with preponderance of fibrosis (TRG 3), fibrosis with preponderance of tumor cells (TRG 4) or tumor without changes of regression (TRG 5)
Microscopic (histologic) images
Cytology description
Positive stains
- Immunohistochemistry is not usually required to make the diagnosis
- Immunohistochemistry is used to confirm the HER2 status (with HER2 in situ hybridization if required), although HER2 expression is heterogenous in 40% of gastric cancers and multiple biopsies are recommended to obtain a meaningful result
- Immunohistochemistry is also important for confirming the PDL1 status
- Immunohistochemistry may also be performed for mismatch repair deficiency which carries a better prognosis than patients that are mismatch repair proficient (Br J Surg 2018;105:159)
Molecular / cytogenetics description
- Next generation sequencing for microsatellite instability (MSI), high tumor mutational burden (TMB) or NTRK gene fusions can be performed to guide targeted therapeutic agents as per the National Comprehensive Cancer Network Guidance version 2.2022 (NCCN Guidelines: Gastric Cancer [Accessed 9 February 2023])
Sample pathology report
- Stomach, endoscopic mucosal resection:
- Invasive tubular adenocarcinoma, pT1a, N0 (see comment and synoptic report)
- Comment: This specimen comprises nonspecialized gastric mucosa and some submucosa. Moderately differentiated tubular pattern adenocarcinoma is present, composed of irregular glands with nuclear atypia. The tumor measures 12 mm in width and invades into the muscularis mucosae but does not extend into the included submucosa. There is no evidence of lymphovascular or perineural invasion. The tumor lies 3 mm from the peripheral mucosal margin and 2 mm clear of the deep margin. The adjacent mucosa shows chronic gastritis with intestinal metaplasia and foci of high grade dysplasia.
Differential diagnosis
- Other patterns of primary gastric carcinoma (e.g., poorly cohesive carcinoma):
- Sheets of poorly cohesive atypical epithelial cells that may be present as small clusters of cells or as individual cells
- May have a signet ring morphology
- Metastatic carcinoma from other primary sites (e.g., invasive ductal carcinoma of the breast or non-small cell carcinoma of the lung):
- Immunohistochemistry may be required (e.g., for breast carcinoma - GATA3 and estrogen receptors)
- Clinical history will be very useful in these cases
Practice question #1
Which of the following conditions may be a differential diagnosis of well / moderately differentiated tubular or papillary gastric adenocarcinoma on biopsy?
- Epithelioid pattern gastrointestinal stromal tumor
- Invasive ductal carcinoma of the breast
- Marginal zone lymphoma
- Small cell carcinoma of the lung
- Synovial sarcoma
Practice answer #1
B. Invasive ductal carcinoma of the breast. Metastatic invasive ductal carcinoma of the breast commonly possesses a tubular type growth pattern and therefore could mimic tubular pattern gastric adenocarcinoma. In contrast, epithelioid pattern gastrointestinal stromal tumors will appear less pleomorphic and will show no tubular or papillary growth patterns and the immunohistochemical expression profile will differ from adenocarcinoma. Marginal cell lymphoma comprises sheets of small lymphoid cells, sometimes showing plasmacytic differentiation and lymphoepithelial lesions. Small cell carcinoma comprises sheets of epithelial cells with inconspicuous cytoplasm, exhibiting nuclear molding and showing a high mitotic and apoptotic index, often with areas of necrosis. Synovial sarcoma is usually a biphasic tumor with a predominant spindle cell component and characteristic immunohistochemical expression profile.
Comment Here
Reference: Intestinal type adenocarcinoma
Comment Here
Reference: Intestinal type adenocarcinoma
Practice question #2
Which of the following is a risk factor for gastric adenocarcinoma?
- Autoimmune gastritis
- Bile reflux into the stomach
- Fundic gland polyps
- Nonsteroidal anti-inflammatory drug use
- Peptic ulceration of the stomach
Practice answer #2
A. Autoimmune gastritis leads to destruction of gastric parietal cells, hypochlorhydria and bacterial overgrowth, with the resultant production of carcinogens within the stomach. In contrast, bile reflux and nonsteroidal anti-inflammatory drugs lead to a reactive / chemical gastropathy but are not associated with gastric atrophy / adenocarcinoma. Fundic gland polyps only very rarely contain areas of dysplasia. Peptic ulceration most commonly occurs due to Helicobacter associated gastritis but is not an independent risk factor for adenocarcinoma.
Comment Here
Reference: Intestinal type adenocarcinoma
Comment Here
Reference: Intestinal type adenocarcinoma